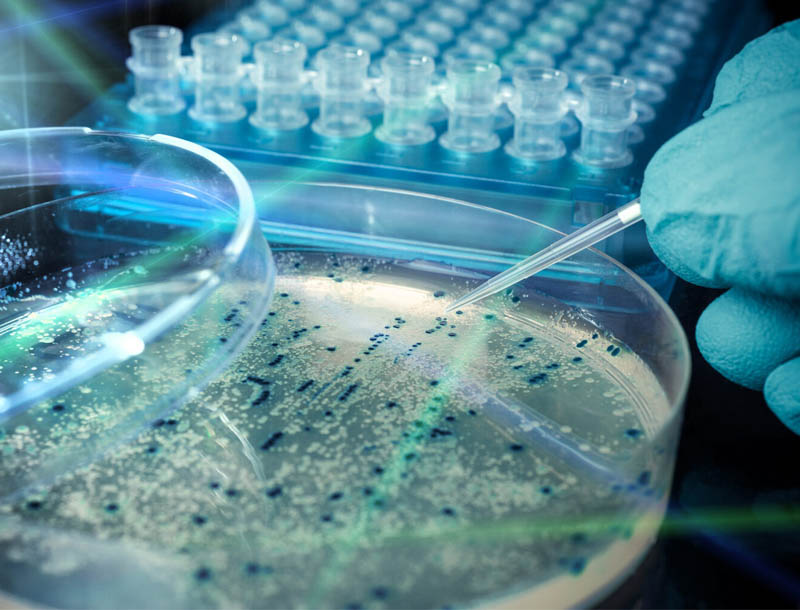

Por Shana K. Hutchins
Las bacterias resistentes a los antibióticos se han convertido en una amenaza cada vez mayor para la salud pública. Cada año, representan más de 2,8 millones de infecciones, según los Centros para el Control y la Prevención de Enfermedades de EE. UU. Sin nuevos antibióticos, incluso las lesiones e infecciones comunes albergan el potencial de volverse letales.
Los científicos ahora están un paso más cerca de eliminar esa amenaza, gracias a una colaboración liderada por la Universidad Texas A&M que ha desarrollado una nueva familia de polímeros capaces de matar bacterias sin inducir resistencia a los antibióticos al alterar la membrana de estos microorganismos.
El Dr. Quentin Michaudel, profesor asistente en el Departamento de Química es el director investigador en la investigación. Trabajando en la interfaz de la química orgánica y la ciencia de los polímeros, el Laboratorio Michaudel pudo sintetizar el nuevo polímero diseñando cuidadosamente una molécula cargada positivamente que se puede unir muchas veces para formar una molécula grande hecha del mismo motivo cargado repetitivo utilizando un material cuidadosamente seleccionado, un catalizador llamado AquaMet. Según Michaudel, ese catalizador resulta clave, dado que debe tolerar una alta concentración de cargas y además ser soluble en agua, una característica que él describe como poco común en este tipo de procesos.
Después de lograr el éxito, el Laboratorio Michaudel puso a prueba sus polímeros contra dos tipos principales de bacterias resistentes a los antibióticos: E. coli y Staphylococcus aureus (MRSA), en colaboración con el grupo de la Dra. Jessica Schiffman de la Universidad de Massachusetts Amherst. Mientras esperaban esos resultados, los investigadores también probaron la toxicidad de sus polímeros contra los glóbulos rojos humanos.
Michaudel atribuye la naturaleza multidisciplinaria de la innovación científica y la generosidad de los investigadores dedicados en todo el campus y el país de Texas A&M como factores en el éxito de su equipo a la hora de determinar el catalizador perfecto para el ensamblaje de sus moléculas.
Michaudel dice que el equipo ahora se centrará en mejorar la actividad de sus polímeros contra las bacterias (específicamente, su selectividad por las células bacterianas frente a las células humanas) antes de pasar a los ensayos in vivo.